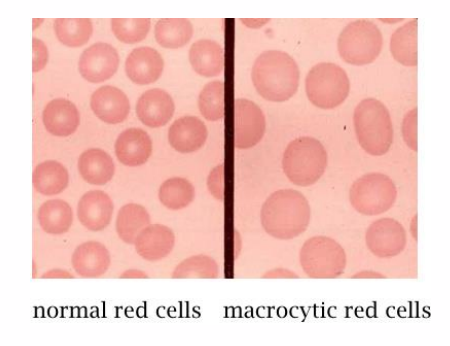
<p>Folate (Vitamin B9) Deficiency: Macrocytic Anemia</p>

IMED1004 - Micronutrients 2 (L18)
1/55
There's no tags or description
Looks like no tags are added yet.
Name | Mastery | Learn | Test | Matching | Spaced | Call with Kai |
|---|
No study sessions yet.
56 Terms
B Vitamin Deficiencies
Causes relating to low intake:
- processed foods (white rice, white flour)
- severe malnutrition
- bariatric surgery (reduction of stomach)
- inappropriate parental nutrition (providing nutrition intravenously)
CAUSES RELATING TO MALABSORPTION:
- Heavy alcohol use (especially thiamine, niacin, vitamin B6, folate)
- diseases which damage the intestines - inflammatory bowel disease (crohn's disease), celiac disease
B vitamins are ___________ soluble
water soluble
Symptoms of B vitamin deficiencies
- many signs and symptoms of different deficiencies are similar
- Primary deficiency of single micronutrient alone is uncommon (primary deficiency mostly seen in Severe Acute Malnutrition (SAM). It involes insufficient dietary intake of several micronutrients
- Secondary malnutrition is much more common (primary pathologies affect the absorption, metabolism, requiremeents, storages, wasting of specific micronutrients differently
Alcohol Dependence and Vitamin Deficiency
EFFECTS OF ALCOHOL DEPENDENCE:
- Alcohol may displace other foods from diet - decreased intake, increases risk of primary malnutrition
- Alcohol inhibits reactions: digestion of vitamers in foods allow for absorption
- Damage to intestines: reduced absorption
- Damage to liver: reduced capacity for metabolism, storage
- Overall: increased requirements
.
SECONDARY MALNUTRITION:
- Gastrointestinal (GI) disease
- Chronic wasting diseases
- Acute critical ilness
These result in:
- malabsorption
- impaired use
- impaired storage
- excessive losses
- increased requirements
B Vitamin Deficiency Genetic Aeitologies
- genetic disorders affecting transporters impair absorption by enterocytes
- dietary sources of many vitamins are digested to "free" form, absorbed
- High doses of some vitamins (as in supplements) can enter enterocytes by diffusion
- Many B vitamins are coenzymes
- Genetic disorders affecting those enzymes can mimic deficiency

Shared signs of deficiency in different B vitamins
DIAGRAM ON SLIDE 7


B vitamins (energy production, nutrient metabolism)
- B1: Thiamin, cofactor: TPP
- B2: Riboflavin, cofactor: FAD, FMN
- B3: Niacin, cofactor: NAD+, NADP
- B5: Panthothenic acid, cofactor: CoA
- B6: Pyridoxine + Pyridoxamine, cofactor: PLP
- B7: Biotin, cofactor: biotin
- B9: Folate, cofactor: THF
- B12: Cobalamin, cofactor: B12
.
- just have to know whats circled


RECALL: Cofactors are required for enzyme function (NO LEARNING OUTCOME)
- Coenzymes: organic molecules function as cofactors in enzymatic reactions
- Can be used to carry chemical groups, electrons
- Changed by enzymatic reaction, but is regenerated
- Prosthetic groups: remain bound to enzyme
- Cosubstrates: transiently bound


B vitamins serve as cofactors for the enzymes in many metabolic pathways, including:
- nucleotide metabolism
- carbohydrate metabolism
- energy metabolism
- neurotransmitter synthesis
- Metabolism of other cofactors (includiing other B vitamins)
- B vitamins serve as cofactors for many metabolic enzymes


Role of vitamin-derived cofactors in metabolic pathways
DIAGRAM ON SLIDE 11


How vitamins are written
It is the letter (e.g B) and then a SUBSCRIPT of the number)
- it is not VItamin B1 it is Vitamin B (subscript 1)


Thiamin (Vitamin B1) Sources, Absorption
Thiamine diphosphate (TDP) is the active vitamer
- Synonym: TPP - thiamine pyrophosphate
- Digestion: hydrolysis to thiamine monophosphate (free thiamine is absorbed)
- Phosphorylation, hydrolysis occurs in tissues
.
Lost in processing of grains; cooking:
- Unstable in heat, alkaline conditions
,
IMPORTANT: TDP is a cofactor for many decarboxylation reactions
.
- many B vitamins have to be digested to a free form to be absorbed. It is phosphorylated back to TDP so that it is put in its active form again


Thiamin (Vitamin B1) Functions
- TDP is a cofcator for many decarboxylation reactions
- Energy production and nutrient metabolism (Pyruvate dehydrogenase, alpha ketoglutarate dehydrogenase, branched-chain alpha-keto acid dehydrogenase complexes)
- Metabolites for nucleotide synthesis (via PPP) (transketolase)
- Nervous system functions (not as a coenzyme)


Thiamin (Vitamin B1) Pentose Phosphate Pathway
- Cofactor for transketolases
- Enzymes in the non-oxidative phase or PPP (Pentose Phosphate Pathway)
- NADPH for redox homeostasis, biosynthetic processes (including syntheses of fatty acids, tetrahydrofolate, cholesterol)
- Ribose 5-P for syntheses of nucleotides, coenzymes, DNA, RNA

Thiamin (Vitamin B1) Deficiency
PRIMARY DEFICIENCY:
- Now uncommon, except in displaced populations (e.g refugee populations)
- Diet of polished (white) rice is a cause. Supplementing or rice bran ensures adequate intake
- In Australia, bread must be fortified
SECONDARY DEFICIENCY:
- Hyperemesis gravidarum
- Diabetes
- Dialysis
- Alcohol Dependency
ALCOHOL DEPENDENCY:
- Displaces consumption of other foods
- Absorption inhibited by alcohol
- Utilisation inhibited by alcohol
Thiamin (Vitamin B1) Deficiency - Wernicke-Korsakoff Syndrome
- Alcohol Dependency:
- Ataxia
- Ocular Muscle Dysfunction
- Delirium
- Short-term memory loss
Thiamin (Vitamin B1) Deficiency - Beriberi
- weakness
- nervous system (peripheral neuropathy, mental abnormalities, ataxia)
- cardiovascular system (tachycardia, peripheral edema, cardiomegaly)
- Muscle weakness, wasting
- Lactic acidosis

Riboflavin (Vitamin B2) Sources
ACTIVE COENZYMES ARE:
- flavin mononucleotide (FMN) and flavin adenine dinucleotide (FAD)
- grains contain riboflavin in bran and germ layers, lost in refining process
- Some riboflavin is synthesised by intestinal bacteria, and can be absorbed


Riboflavin (Vitamin B2) Absorption
ACTIVE COENZYMES ARE:
- flavin mononucleotide (FMN) and flavin adenine dinucleotide (FAD)
DIGESTION:
- intestinal. Phosphatases hydrolyse riboflavin from FAD, FMN
ABSORPTION:
- carrier-mediated transport in small intestine, colon
.
- Alcohol inhibits both digestion and absorption
.
- the active coenzyme in the diagram may be present in foods, but in order to be transported by carriers in our small intestine and colon, these must be digested or hydrolysed back to riboflavin and they're resynthesised back into the active coenzymes after they have been absorbed.


Riboflavin (Vitamin B2) Functions
- FMN (flavin mononucleotide) and FAD (flavin adenine dinucleotide) are electron acceptors
Many redox enzymes have flavin prosthetic groups:
- TCA Cycle
- Beta oxidation of fatty acids
- The electron transport chain


Riboflavin (Vitamin B2) Deficiency: Ariboflavinosis
- Symptoms common to many B vitamin deficiencies (inflammation of the lining of mouth and tongue, dry and scaling skin, keratitis, dermatitis)
- Rarely occurs without other deficiency
SECONDARY DEFICIENCY IS RARE:
- Inborn errors of metabolism, non-functional riboflavin transporter; riboflavin-dependent enzymes


Niacin (Vitamin B3)
2 FORMS (VITAMERS):
- Nicotinic acid
- nicotinamide
COENZYMES ARE:
- NAD+ (nicotinamide adenine dinucleotide)
- NADP+ (nicotinamide adenine dinucleotide phosphate)


Niacin (Vitamin B3) Functions
- Coenzyme for more then 200 enzymes in redox reactions (function as electron acceptors (hydrogen donors))
- Donor of adenosine diphosphate ribose (G protein activity, Chromatin structure, intracellular calcium signalling via cyclic ADP-ribose, DNA repair, replication, transcription


Niacin (Vitamin B3) Deficiency: Pellagra
- "the 4 D's"
DIARRHOEA:
- niacin has an anti-inflammatory role in digestive tract
DERMATITIS:
- UV damage to DNA
- Deficiency: impaired repair mechanism
DEMENTIA:
- Deficiency: cyclic ADP-ribose generation disrupted
- altered calcium signalling (since Ca2+ is released from RyR due to Cyclic ADP-ribose)
DEATH
.
PRIMARY DEFICIENCY VERY RARE
- alcohol dependancy
- populations where bulk of diet comes from corn
.
REASONS FOR THESE:
- diarrhoea happens because niacin is involved in anti-inflammatory role in digestive tract
- dermatitis occurs becuase niacin has a role in repairing damaged DNA due to UV, so lack of it means u cant repair skin
- dementia occurs because of altered calcium signalling due to disruption in generation of cyclic ADP ribose


Pellagra and high-corn diets
- Niacin - not bioavailable in corn: Pellagra common in Europe 1700s, southern US 1900s
- Process corn to yield bioavailable niacin (Soak corn meal in alkaline solution + heat)
- Pellagra is uncommon in South America, despite high corn diet


Niacin (Vitamin B3) Sources: Synthesis from Tryptophan
Liver can synthesise NAD from tryptophan:
- Tryptophan is an essential AA
- 60mg of tryptophan -> 1 mg of NAD
- Requires vitamin B6
.
- Gut bacteria may also convert Trp -> NAD+
- Both processes are inefficient and very slow
- Most Vitamin B3 (niacin) is supplied through the diet


Secondary Deficiency
- impaired absorption (chronic diarrhea, intestinal cancer)
- Hartnup disease: genetic disorder of tryptophan transporters (impaired tryptophan absorption, secondary niacin deficiency can occur)
SOME DRUGS INHIBIT CONVERSION OF TRYPTOPHAN INTO NIACIN, INCLUDING:
- azathioprine/mercaptopurine (immunosuppressant, chemotherapy)
- chloramphenicol (antibiotic)
- Phenobarbital (anti-seizure medication)
.
- dont need to remember the names of the drugs that inhibit conversion, just need to know that it happens

Niacin (Vitamin B3) High doses for hyperlipidaemia, side effects
- RDI: 16mg/day
- Extremely high doses (6g/day) can be used to treat hyperlipidaemia
- Lower serum cholesterol, LDL
- increases HDL
- mechanisms unclear: potentially via interactions with G protein coupled receptors, enzymes
.
Doses >50mg - 1g/day have side effects
- flushing/redness in skin
- Burning, itching, tingling, headaches
- Nausea, vomiting, hyperglycaemia
.
High-dose niacin (nicotinic acid) can help manage hyperlipidaemia by improving cholesterol levels and triglycerides in the blood, though not without significant side effects like flushing and potential hepatotoxicity. It works by decreasing LDL ("bad") cholesterol and triglycerides, and increasing HDL ("good") cholesterol. Niacin achieves this by inhibiting the liver's production of VLDL (very-low-density lipoprotein), which is a precursor to LDL, and by boosting HDL levels

Pantothenic Acid (Vitamin B5) Sources
- present in almost all plant, animal foods
- Not stable in alkaline, acidic conditions
- Freezing, canning, refining foods results in losses of up to 75%
- Pantothenic acid used to synthesise CoA within cells
- CoA binds to a range of carboxylic acids; functions as acyl (acetyl) carrier


Pantothenic Acid (Vitamin B5) Functions
- Extensive role in nutrient metabolism
- common intermediate (carbohydrate, lipid, protein catablism but also fatty acid, ketone synthesise and AA synthesis (via TCA Cycle intermediates)
- Cholesterol synthesis (bile, steroid hormones, vitamin D)
- Neurotransmitters (acetylcholine (cholinergic neurons))
- Epigenetic modifications (histone acetylation, promotes gene expression)

Panthothenic Acid (Vitamin B5) Deficiency: "Burning Foot Syndrome"
PRIMARY DEFICIENCY:
- Extremely rare - only in severe malnutrition; co-occurs with other nutrient deficiencies
- Present in almost all foods
- No non-experimental syndrome recognised
SECONDARY DEFICIENCY:
- Defects in pathway for CoA synthesis can occur
.
- Gastrointestinal distress
- Issues with growth
- Fatigue
- Cramping
- Restlessness (Diverse symptoms due to diverse roles)

Pyruvate Dehydrogenase and its cofactors
DIAGRAM ON SLIDE 32


B Vitamins: Gene Expression
DIAGRAM ON SLIDE 33


Vitamin B6 Sources, Absorption
6 vitamers: Pyridoxine, Pyridoxal, pyridoxamine + phosphorylated form of each
- Found in plant - and animal derived foods
DIGESTION:
- Alkaline phosphotase dephosphorylates phosphorylated vitamers to corresponding free vitamers
ABSORPTION:
- Free vitamers absorbed by passive diffusion in jejunum


Vitamin B6 Function
- PLP is a cofactor for around 4% of all enzymes
- Amino acid catabolism (threonine aldolase)
- Amino acid synthesis (transamination reactions)
- Neurotransmitter synthesis (decarboxylation)
- Haem synthesis (with folate)
- Synthesis of NAD from tryptophan

Vitamin B6 Deficiency
PRIMARY DEFICIENCY IS RARE
- Present in most food
SECONDARY DEFICIENCY IS DUE TO:
- Crohn's, celiac diseases (malabsorption)
- High levels of alcohol use (impairs metabolism to active vitamer)
- Systemic inflammation, old age (increases vitamin catabolism)
- Pyridoxine-inactivating drugs e.g corticosteroids
- Haemodialysis
SKIN:
- Dermatitis
- Stomatitis
- Glossitis
NEURLOGICAL:
- Depression
- Confusion
- Seizures
- Peripheral neuropathy
MICROCYTIC ANAEMIA
Vitamin B6 Toxicity
RDL: 1.3mg
- intake over 200mg/day results in sensory and peripheral neuropathy
- intake over 2g/day results in impaired motor control, ataxia and degeneration of neurons

Biotin (Vitamin B7) Sources, Absorption
DIGESTION: in diet, bound to proteins
- intestinal proteases: yield free biotin, biocytin
- Biotinidase: hydrolyses biocytin to free biotin, lysine
- ABSORPTION: free biotin
- BIOTIN IS SYNTHESISED BY GUT BACTERIA: contribution is unclear, but insufficient to meet physiological requirements
- BIOTINIDASE DEFICIENCY: inborn error of metabolism, impairs digestion and bioavailability


Biotin (Vitamin B7) Functions
PROSTHETIC GROUP FOR CARBOXYLASE ENZYMES:
- Long, flexible AA chain connects biotin to apoenzyme
- facilitates transfer of carbon dioxide (as "activated bicarbonate") between active sites
- Requires holocarboxylase synthase - binds biotin to enzyme
.
ROLES IN:
- catabolism of leucine, isoprenoids
- AA, FA metabolism
- Gluconeogenesis: Pyruvate carboxylase
- FA Synthesis: Acetyl CoA carboxylase


Biotin in gluconeogenesis, FA and AA catabolism, FA synthesis
DIAGRAM ON SLIDE 40


Biotin (Vitamin B7) Deficiency
PRIMARY DEFICIENCY IS RARE:
- No defined deficiency syndrome
- Additionally, some synthesised by intestinal bacteria
SECONDARY DEFICIENCY:
- Consumption of egg whites (protein (avidin) from egg white binds biotin very strongly)
- Biotinidase deficiency
- Holocarboxylase synthase deficiency
.
- dermatitis around eyes, nose and mouth
- alopecia
- neurologic symptoms (lethargy, hallucinations)


B Vitamins: Haematopoiesis
- see whats circled


Folate (Vitamin B9) sources
FOLIC ACID:
- supplements, fortified foods
- oxidised form
- stable
- 100% folic acid absorbed
- stable
FOLATE:
- dietary source
- reduced form
- unstable: degraded by cooking
- predominantly as polyglutamate
- 50% dietary folate absorbed (highly variable)
.
- requirements stated as "folate equivalents"


Folate (Vitamin B9) Functions
- Many derivatives (vitamers)
- All accept/donate one carbon units
Cosubstrates for a range of reactions involved in:
- nutrient metabolism
- energy production
- gene expression
IMPORTANT ONES:
- haematopoiesis
- nucleotide synthesis
- DNA methylation


Folate (Vitamin B9) Functions Pyrimidines and Purines
- required for synthesis of both pyrimidines and purines
- Without folate, DNA synthesis is impaired
- Deficiency: increased cancer risk (decreased nucleotide production, aberrant methylation)


Folate (Vitamin B9) Absorption
PCFT: proton-coupled folate transporter
- duodenum, proximal jejunum
- PCFT only transports monoglutamate form of folate
- polyglutamate folate in diet must be converted to monoglutamate form for absorption
- Reaction facilitated by enzymes which remove (hydrolyse) glutamate


Folate (Vitamin B9) Deficiency
PRIMARY DEFICIENCY IS RARE:
PCFT: protein coupled folate transporter
- duodenum, proximal jejunum (celiac disease: affects these regions of small intestine)
- Hereditary folate malabsorption (rare, cause is genetic defect in transporter, treatment is IV folate infusions)

Folate (Vitamin B9) Deficiency: Macrocytic Anemia
- effects cells with rapid turnover (e.g GI tract, symptom: glossitis)
- Defective maturation of red blood cells
- Macrocytic anaemia (decreased nucleotide availability causes deranged haematopoiesis, immature and large RBCs as well as RBCs have decreased lifespan, capacity for oxygen transport


Folate (Vitamin B9) Deficiency: Spina Bifida
Special case: pregnancy
- Deficiency: neural tube defects (spina bifida)
- Neural tube closes 21-28 days after conception - may not know are pregnant
- Supplementation of grains is a public health success story
- However: supplements + fortification can result in toxicity (insomnia, malaise, irritability, GI distress)


Vitamin B12 Deficiency impacts folate function
- "methyl folate trap"
- Methionine synthase (prosthetic group: B12, Methyl group: 5-methyl THF)
- Deficiency in B12 results in folate "trapped" as 5-methyl-THF
- folate cannot be converted to appropriate form for use in nucleotide synthesis
- B12 deficiency also causes megaloblastic anemia
- Excess consumption of folate can mask B12 deficiency - dangerous


Vitamin B12 Functions
- Macrocyclic ring with cobalt at centre
- Vitamers (Differ by groups bound cobalt)
- Cofactor in reactions forming: methionine, succinyl CoA


Vitamin B12 Absorption
- intrinsic factor (IF): glycoprotein
- Enterocytes import B12-IF complex via receptor-mediated endocytosis
- Enterohepatic circulation (secreted in bile, reabsorbed in ileum, long biological half-life)

Vitamin B12 Deficiency
- 30-40% of adults are deficient
- Improper management of vegetarian diet (not present in plant-based foods)
- Poor absorption (intestinal parasites, pernicious anaemia, removal of stomach, genetic disorders. Disease affecting ileum reduce absorption (e.,g Crohn's disease)
- Receptor-mediated uptake - requires intrinsic factor (genetic disorders)
.
UNLIKE OTHER WATER SOLUBLE VITAMINS, THERE ARE SUBSTANTIAL BIOLOGICAL STORES
- sufficient to serve biological needs for 3-5 years
- Mostly in liver (2-5g)
- Deficiency progresses in stages as stores deplete

Vitamin B12 Deficiency Problems
- Macrocytic Anaemia (methyl folate trap)
NEUROLOGICAL PROBLEMS:
- Irritability, memory loss, dementia, poor coordination, numbness. Some are irreversible
.
CAUSED BY DEMYELINATION:
- mechanism unclear
- associated with increases in methylmalonic acid - may destabilise myelin, form abnormal myelin


SUMMARY
DIAGRAM ON SLIDE 55

How to remember B vitamins
the rabbit notes panthers and pythons be fierce carnivores